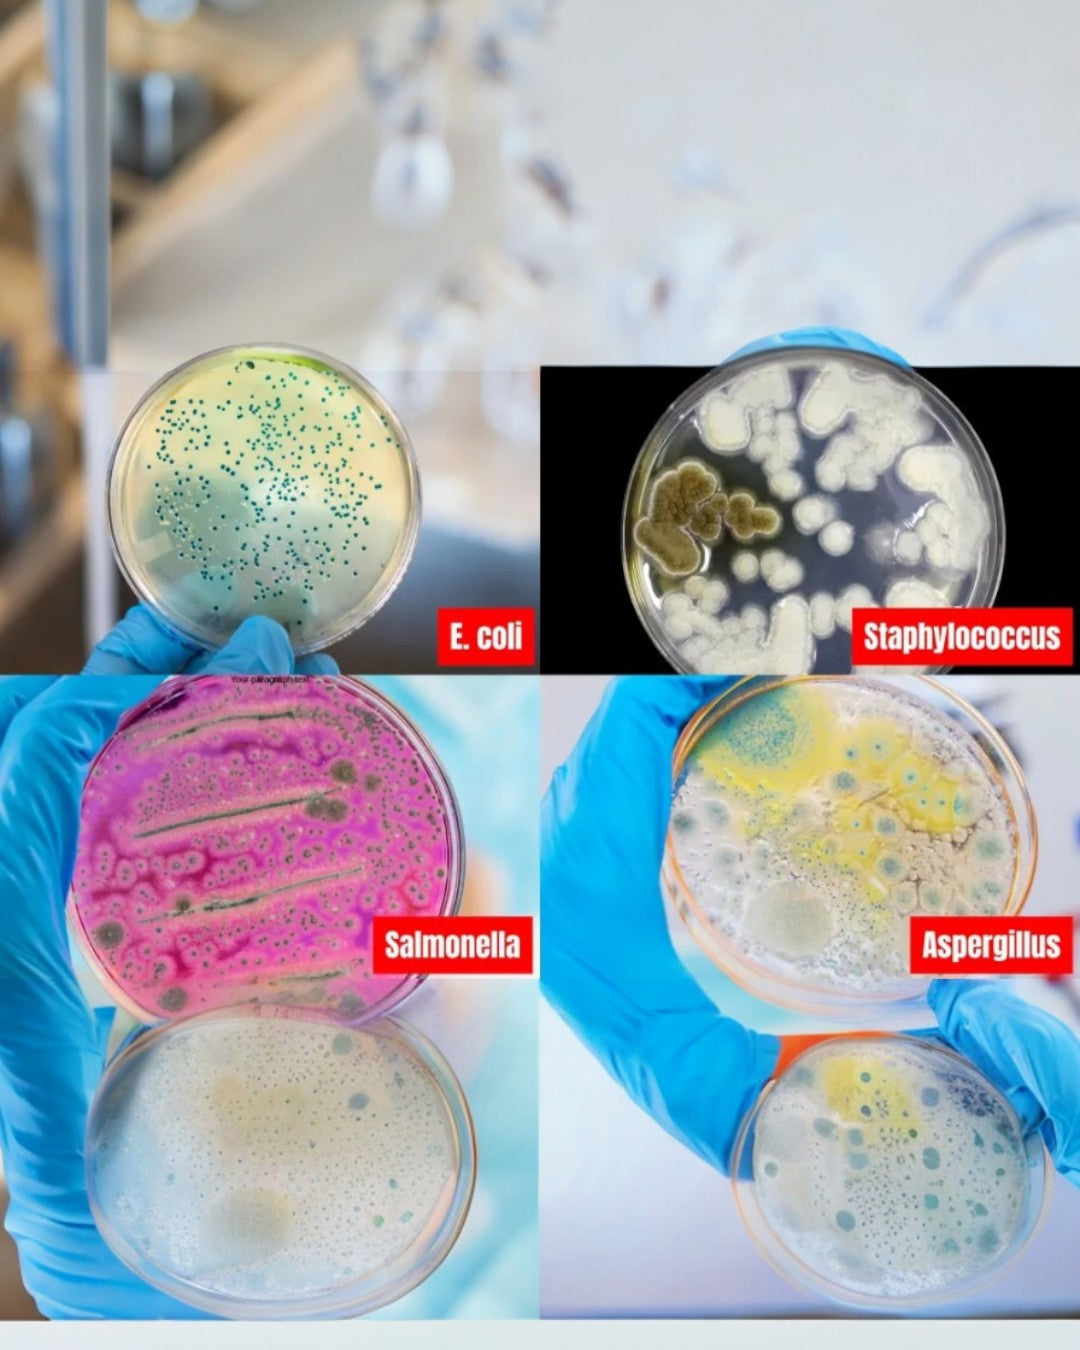

-
Free shipping over 70$
-
30-Day Money-Back Guarantee
-
Secure Checkout
Precision Cleaning for Every Corner
The angled brush head and flexible handle reach deep into corners, edges, and tight spaces—removing grime and hidden buildup regular tools can’t touch.
Triple Cleaning Power for Your Home
Dual-speed rotation up to 235 RPM breaks through hidden dirt, UV detection reveals invisible bacteria, and the ergonomic handle keeps every corner spotless with zero effort.
Powerful Cleaning for the Toughest Corners
Reaches deep into tight spaces and hard-to-clean edges—N-CLEAN PRO 7 removes grime, mold, and buildup where regular tools can’t.
From Grease and Stains to Crystal Clarity
Built-up grease, water marks, and stubborn soap scum disappear in seconds with N-CLEAN PRO 7. Its high-speed rotation effortlessly polishes oven glass, mirrors, and tiles — restoring a spotless, streak-free shine without any scrubbing.
Flawless Shine on Every Glass Surface
Say goodbye to fingerprints, soap residue, and cloudy streaks. N-CLEAN PRO 7 glides effortlessly across glass, mirrors, and shower doors — restoring crystal-clear brilliance and a showroom-perfect shine in seconds.

The Hidden Health Crisis Inside Your Home
Invisible bacteria thrive on every surface—even the ones that look perfectly clean to the naked eye.
Meet the 4 Most Common Household Threats
E. coli, Staphylococcus, Salmonella, and Aspergillus — all living quietly on your kitchen sponge and countertops.

“Clean” Surfaces Under UV Light
What appears spotless during the day reveals a hidden bacterial jungle under UV detection.

From Grease-Stained to Gleaming Clean
Cut through layers of burnt residue and stubborn grime effortlessly—N-CLEAN PRO 7 restores every surface to a spotless shine in seconds.

From Dull Tiles to Mirror-Like Shine
Watch years of grime disappear in seconds — N-CLEAN PRO 7 restores your floors and grout to a spotless, like-new finish with zero effort.

From Exhausting Scrubbing to Effortless Cleaning
Say goodbye to bending, scrubbing, and back pain. N-CLEAN PRO 7 does the hard work for you—powerful rotation and ergonomic design deliver spotless results in minutes.
Over 13,000 Verified Customers
Make your life easier ! Join thousands of life-changing stories today!






Luxe & Ledger
OUR GARANTEE
Our commitment to customer satisfaction sets us apart. From the moment you choose our products, you can count on us to deliver an exceptional experience. That's why we offer a 30 DAY MONEY BACK GUARANTEE for any issues that may affect your overall satisfaction.







